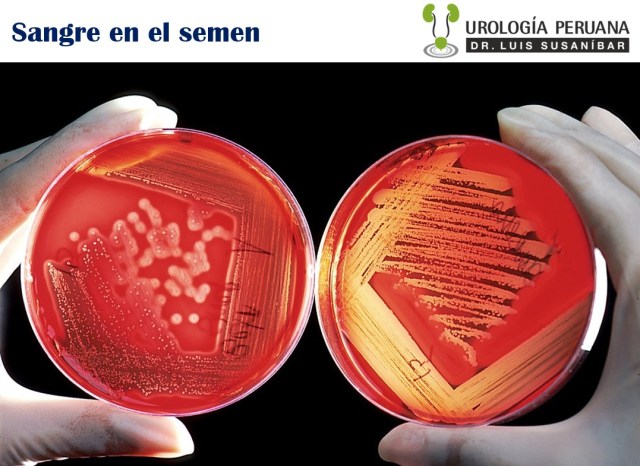

Algunos varones pueden notar durante la eyaculación la presencia de rasgos de sangre en el semen, incluso el eyaculado en su totalidad puede tornarse de un color rosado. Líneas abajo le explicamos a qué se puede deber
Hematospermia
La presencia de sangre en el semen se conoce médicamente como hematospermia o hemospermia, un síntoma que es causa de gran preocupación en el varón y su pareja. Sucede usualmente en varones jóvenes (menores de 40 años) y está asociado a procesos infecciosos e inflamatorios de las vesículas seminales y la próstata, siendo una condición autolimitante.
La hematospermia puede suceder varias veces en el transcurso de la vida del varón adulto sin que se percate de ello, ya que no es usual que visibilice siempre su eyaculado.
Si el episodio se repite con frecuencia o la persona tiene más de 40 años, deberemos evaluar no sólo la presencia de enfermedades de las vías urinarias y del aparato reproductor masculino (testes, próstata y vesículas seminales); sino también enfermedades del hígado y el bazo.
Si tiene sangre en el semen y es mayor de 40 años acuda al urólogo para una evaluación
La hematospermia crónica es una condición en la cual se presentan hematospermia por más de dos meses o 10 eyaculaciones, y ello amerita mayor evaluación, siempre.
Durante el examen clínico debemos poner énfasis en las estructuras anatómicas durante la palpación de las gónadas, de los epidídimos, próstata, vesículas seminales, conductos deferentes y pene.
La el meato y uretra deben inspeccionarse tratando de detectar lesiones que puedan producir sangrado, los conductos deferentes deben ser palpados en toda su longitud en búsqueda de tumoraciones (en algunos casos pueden ser indicativas de tuberculosis). Durante el examen dígito rectal de la próstata además de las características de la glándula NO deben palparse las vesículas seminales, si se palpan debemos sospechar de alguna malignidad. Los varones mayores de 50 años con sangre en el semen siempre deben ser evaluados para descarte de cáncer de próstata.
QUE PUEDE CAUSARLA?
Distintos órganos pueden producir sangrado en el semen
Problemas de la próstata
La primera causa es el sangrado luego de una biopsia de próstata, algo que es evidente durante la evaluación de los antecedentes personales, una biopsia puede ocasionar hemospermia en un variopinto número de pacientes, existen estudios cuyos rangos porcentuales van desde 5 a más del 80%
El cáncer siempre será motivo de discusión, existen algunos trabajos que relacionan esta enfermedad con la presencia de semen sanguinolento, mientras otros autores no encuentran asociación.
Lesiones sangrantes pueden ser evidenciadas durante la cistoscopia, entre ellas las várices y telangectasias prostáticas.
La prostatitis es una causa discutible de esta patología, la mayoría de estudios no han encontrado suficiente asociación para demostrarlo.
La braquiterapia, un modo de tratamiento con semillas radiactivas para el cáncer de próstata, también puede producir este síntoma.
Problemas de la uretra
La uretritis, infección y/o inflamación de la uretra es una causa frecuente en menores de 40 años.
El virus del papiloma puede producir en ocasiones sangrado de uretra, así como quistes, pólipos o estenosis.
Problemas de las vesículas seminales
Los quistes pueden producir hematospermia. En el caso de quistes congénitos es importante señalar que la presencia de quistes puede estar relacionada a agenesia renal o de vasos deferentes ipsilaterales. Ya los quistes adquiridos pueden deberse a infecciones o tumoraciones malignas.
Con el uso de la resonancia magnética se ha podido asociar la presencia de quistes y lesiones hemorrágicas en las vesículas seminales y conductos deferentes, señalados por muchos como las principales causas de hemospermia.
Infecciones
Infecciones por tuberculosis, sida y citomegalovirus han sido asociadas con mucha frecuencia a esta patología. Enfermedades de transmisión sexual han sido evidenciadas en otros estudios, siendo causadas por herpes virus, clamidia, enterococos y ureaplasma.
Enfermedades sistémicas
Muchas enfermedades han sido relacionadas con esta patología, sin embargo no siempre el médico las lleva en mente, entre ellas tenemos la hipertensión, enfermedades crónicas del hígado, amiloidosis, linfomas e incluso la denominada diátesis hemorrágica.
TRATAMIENTO
Al ser una enfermedad que causa mucha ansiedad en el varón, lo primero que debemos hacer es calmarlo, ya que usualmente se autolimita; sin embargo debemos poner especial interés en la hemospermia en tres situaciones:
- Varón de más de 40 años
- Duración de más de 2 meses
- Presencia de sangre en la orina concomitantemente (hematuria)
Se debe identificar el causal, por ejemplo:
- si son infecciones instaurar el tratamiento antibiótico
- si son várices, fulgurarlas
- los quistes pueden ser aspirados en el caso de la próstata
- en algunos pocos casos es necesaria la cirugía de la glándula prostática
Referencias:
1. Leocádio DE, Stein BS. Hematospermia: etiological and management considerations. International Urology and Nephrology. 06/19/2008. 41:77-83
2. Aslam MI, Cheetham P, Miller MA. A management algorithm for hematospermia. Nat Rev Urol. 2009 Jul. 6(7):398-402
3. Ahmad I, Krishna NS. Hemospermia. J Urol. 2007 May. 177(5):1613-8
Dr. Luis Susaníbar Napurí
Especialista en Urología y Medicina Sexual
Contactos:
Consultas: 511 3324009 / Móvil: 511 989662887
Av. Brasil 935. J. María. Av. Nazarenas 695. Surco
www.urologiperuana.com